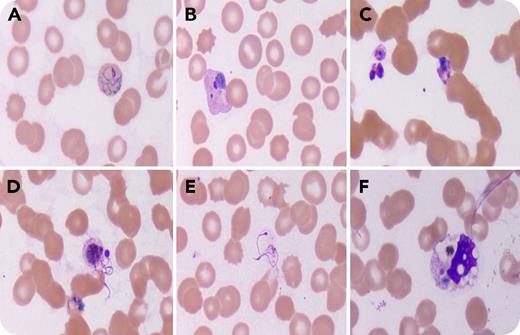
A 23-year-old woman presented with moderate- to high-grade fever for 2 days, multiple episodes of vomiting, and per vaginal bleeding. Physical examination revealed pallor and icterus. There was no organomegaly or lymphadenopathy. Her complete blood count showed anemia (9.1 g/dL) and thrombocytopenia (50 × 103/μL). The peripheral blood film revealed intraerythrocytic Plasmodium vivax forms (panels A-B; original magnification ×1000; Leishman stain). In addition, exflagellation of microgametocytes was noted at different stages (panels C-E; original magnification ×1000; Leishman stain). Also, occasional neutrophils and monocytes showed intracytoplasmic remnants of engulfed parasitic pigment (panel F; original magnification ×1000; Leishman stain). The species identification was also confirmed by using a rapid diagnostic test (SureTest Malaria PF/PV HRP2/pLDH Combo test). In the life cycle of a malaria parasite, the exflagellation of microgametocytes occurs in the stomach of the Anopheles mosquito. One male gametocyte can release up to 8 thin and long microgametes. / Rarely, exflagellation has been reported in the peripheral blood of humans, and the presence of exflagellation might create confusion during diagnosis. The presence of other forms of the parasite and the fact that exflagellation can occur in peripheral blood in P vivax infection will help in arriving at the correct diagnosis.

A 23-year-old woman presented with moderate- to high-grade fever for 2 days, multiple episodes of vomiting, and per vaginal bleeding. Physical examination revealed pallor and icterus. There was no organomegaly or lymphadenopathy. Her complete blood count showed anemia (9.1 g/dL) and thrombocytopenia (50 × 103/μL). The peripheral blood film revealed intraerythrocytic Plasmodium vivax forms (panels A-B; original magnification ×1000; Leishman stain). In addition, exflagellation of microgametocytes was noted at different stages (panels C-E; original magnification ×1000; Leishman stain). Also, occasional neutrophils and monocytes showed intracytoplasmic remnants of engulfed parasitic pigment (panel F; original magnification ×1000; Leishman stain). The species identification was also confirmed by using a rapid diagnostic test (SureTest Malaria PF/PV HRP2/pLDH Combo test). In the life cycle of a malaria parasite, the exflagellation of microgametocytes occurs in the stomach of the Anopheles mosquito. One male gametocyte can release up to 8 thin and long microgametes.
Rarely, exflagellation has been reported in the peripheral blood of humans, and the presence of exflagellation might create confusion during diagnosis. The presence of other forms of the parasite and the fact that exflagellation can occur in peripheral blood in P vivax infection will help in arriving at the correct diagnosis.
A 23-year-old woman presented with moderate- to high-grade fever for 2 days, multiple episodes of vomiting, and per vaginal bleeding. Physical examination revealed pallor and icterus. There was no organomegaly or lymphadenopathy. Her complete blood count showed anemia (9.1 g/dL) and thrombocytopenia (50 × 103/μL). The peripheral blood film revealed intraerythrocytic Plasmodium vivax forms (panels A-B; original magnification ×1000; Leishman stain). In addition, exflagellation of microgametocytes was noted at different stages (panels C-E; original magnification ×1000; Leishman stain). Also, occasional neutrophils and monocytes showed intracytoplasmic remnants of engulfed parasitic pigment (panel F; original magnification ×1000; Leishman stain). The species identification was also confirmed by using a rapid diagnostic test (SureTest Malaria PF/PV HRP2/pLDH Combo test). In the life cycle of a malaria parasite, the exflagellation of microgametocytes occurs in the stomach of the Anopheles mosquito. One male gametocyte can release up to 8 thin and long microgametes.
Rarely, exflagellation has been reported in the peripheral blood of humans, and the presence of exflagellation might create confusion during diagnosis. The presence of other forms of the parasite and the fact that exflagellation can occur in peripheral blood in P vivax infection will help in arriving at the correct diagnosis.
For additional images, visit the ASH Image Bank, a reference and teaching tool that is continually updated with new atlas and case study images. For more information, visit http://imagebank.hematology.org.
This feature is available to Subscribers Only
Sign In or Create an Account Close Modal